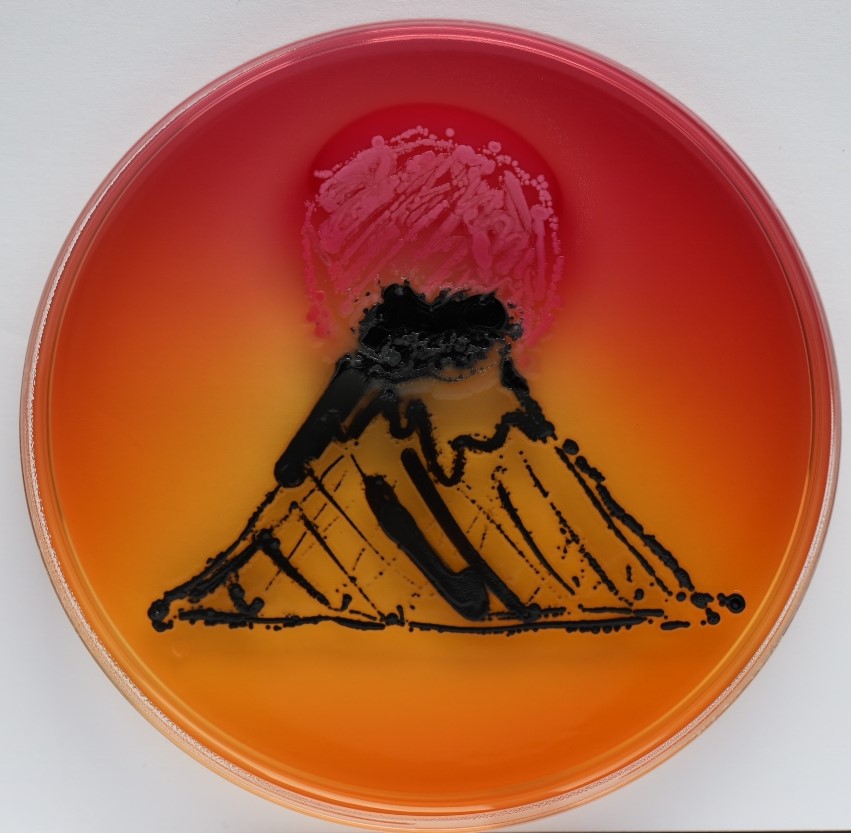
1er prix : J.Joyet

Progressivement, nous faisons évoluer nos moyens de communication, au regard de l’évolution de la situation (confinement).
- – Standard du Lycée : 04 73 41 20 20 tous les jours de 10H00 à 12H00 et de 14H00 à 16H00
- – Au delà de ces horaires, nous sommes joignables par PRONOTE ou par mail :
- – Je vous prie de trouver ci-dessous différentes adresse mail, qui peuvent être utilisées, en plus de PRONOTE :
- – Les Psychologues de l’Education Nationale du lycée sont joignables par mail pour toutes les questions relatives à l’orientation, notamment pour PARCOURSUP :
- – Un RV téléphonique est également possible. N’hésitez pas à les contacter.
- Les infirmières du lycée sont également à votre écoute :
- – L’assistante Sociale du lycée est également à votre écoute
Soyez assurés de notre engagement pour vous aider à surmonter ces moments très difficiles. Cordialement,
Le Proviseur, Christine PELISSIER